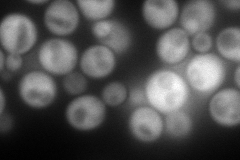
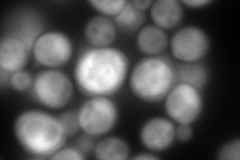

View description
6-phosphogluconate dehydrogenase (decarboxylating), catalyzes an NADPH regenerating reaction in the pentose phosphate pathway; required for growth on D-glucono-delta-lactone
Localization:
Intensity:
Fold change:
Significance:
-
C’ GFP library in SD

below threshold19.54 -
N' NOP1pr-GFP in SD
cytosol247.474 -
N' TEF2pr-mCherry in SD
cytosol408.824 -
N' NATIVEpr-GFP in SD

below threshold27.9909 -
N' TEF2pr-VC and Cyto-VN in SD

cytosol82.7308 -
C’ GFP library in SD+DTT

cytosol25.171.28No -
C’ GFP library in SD+H2O2

cytosol23.41.19No -
C’ GFP library in Starvation Media

cytosol88.954.55No -
C’ GFP library on the background of Pup2-DaMP

below threshold -
C’ GFP library on the background of CCT mutant

below threshold24.66271.26169No
